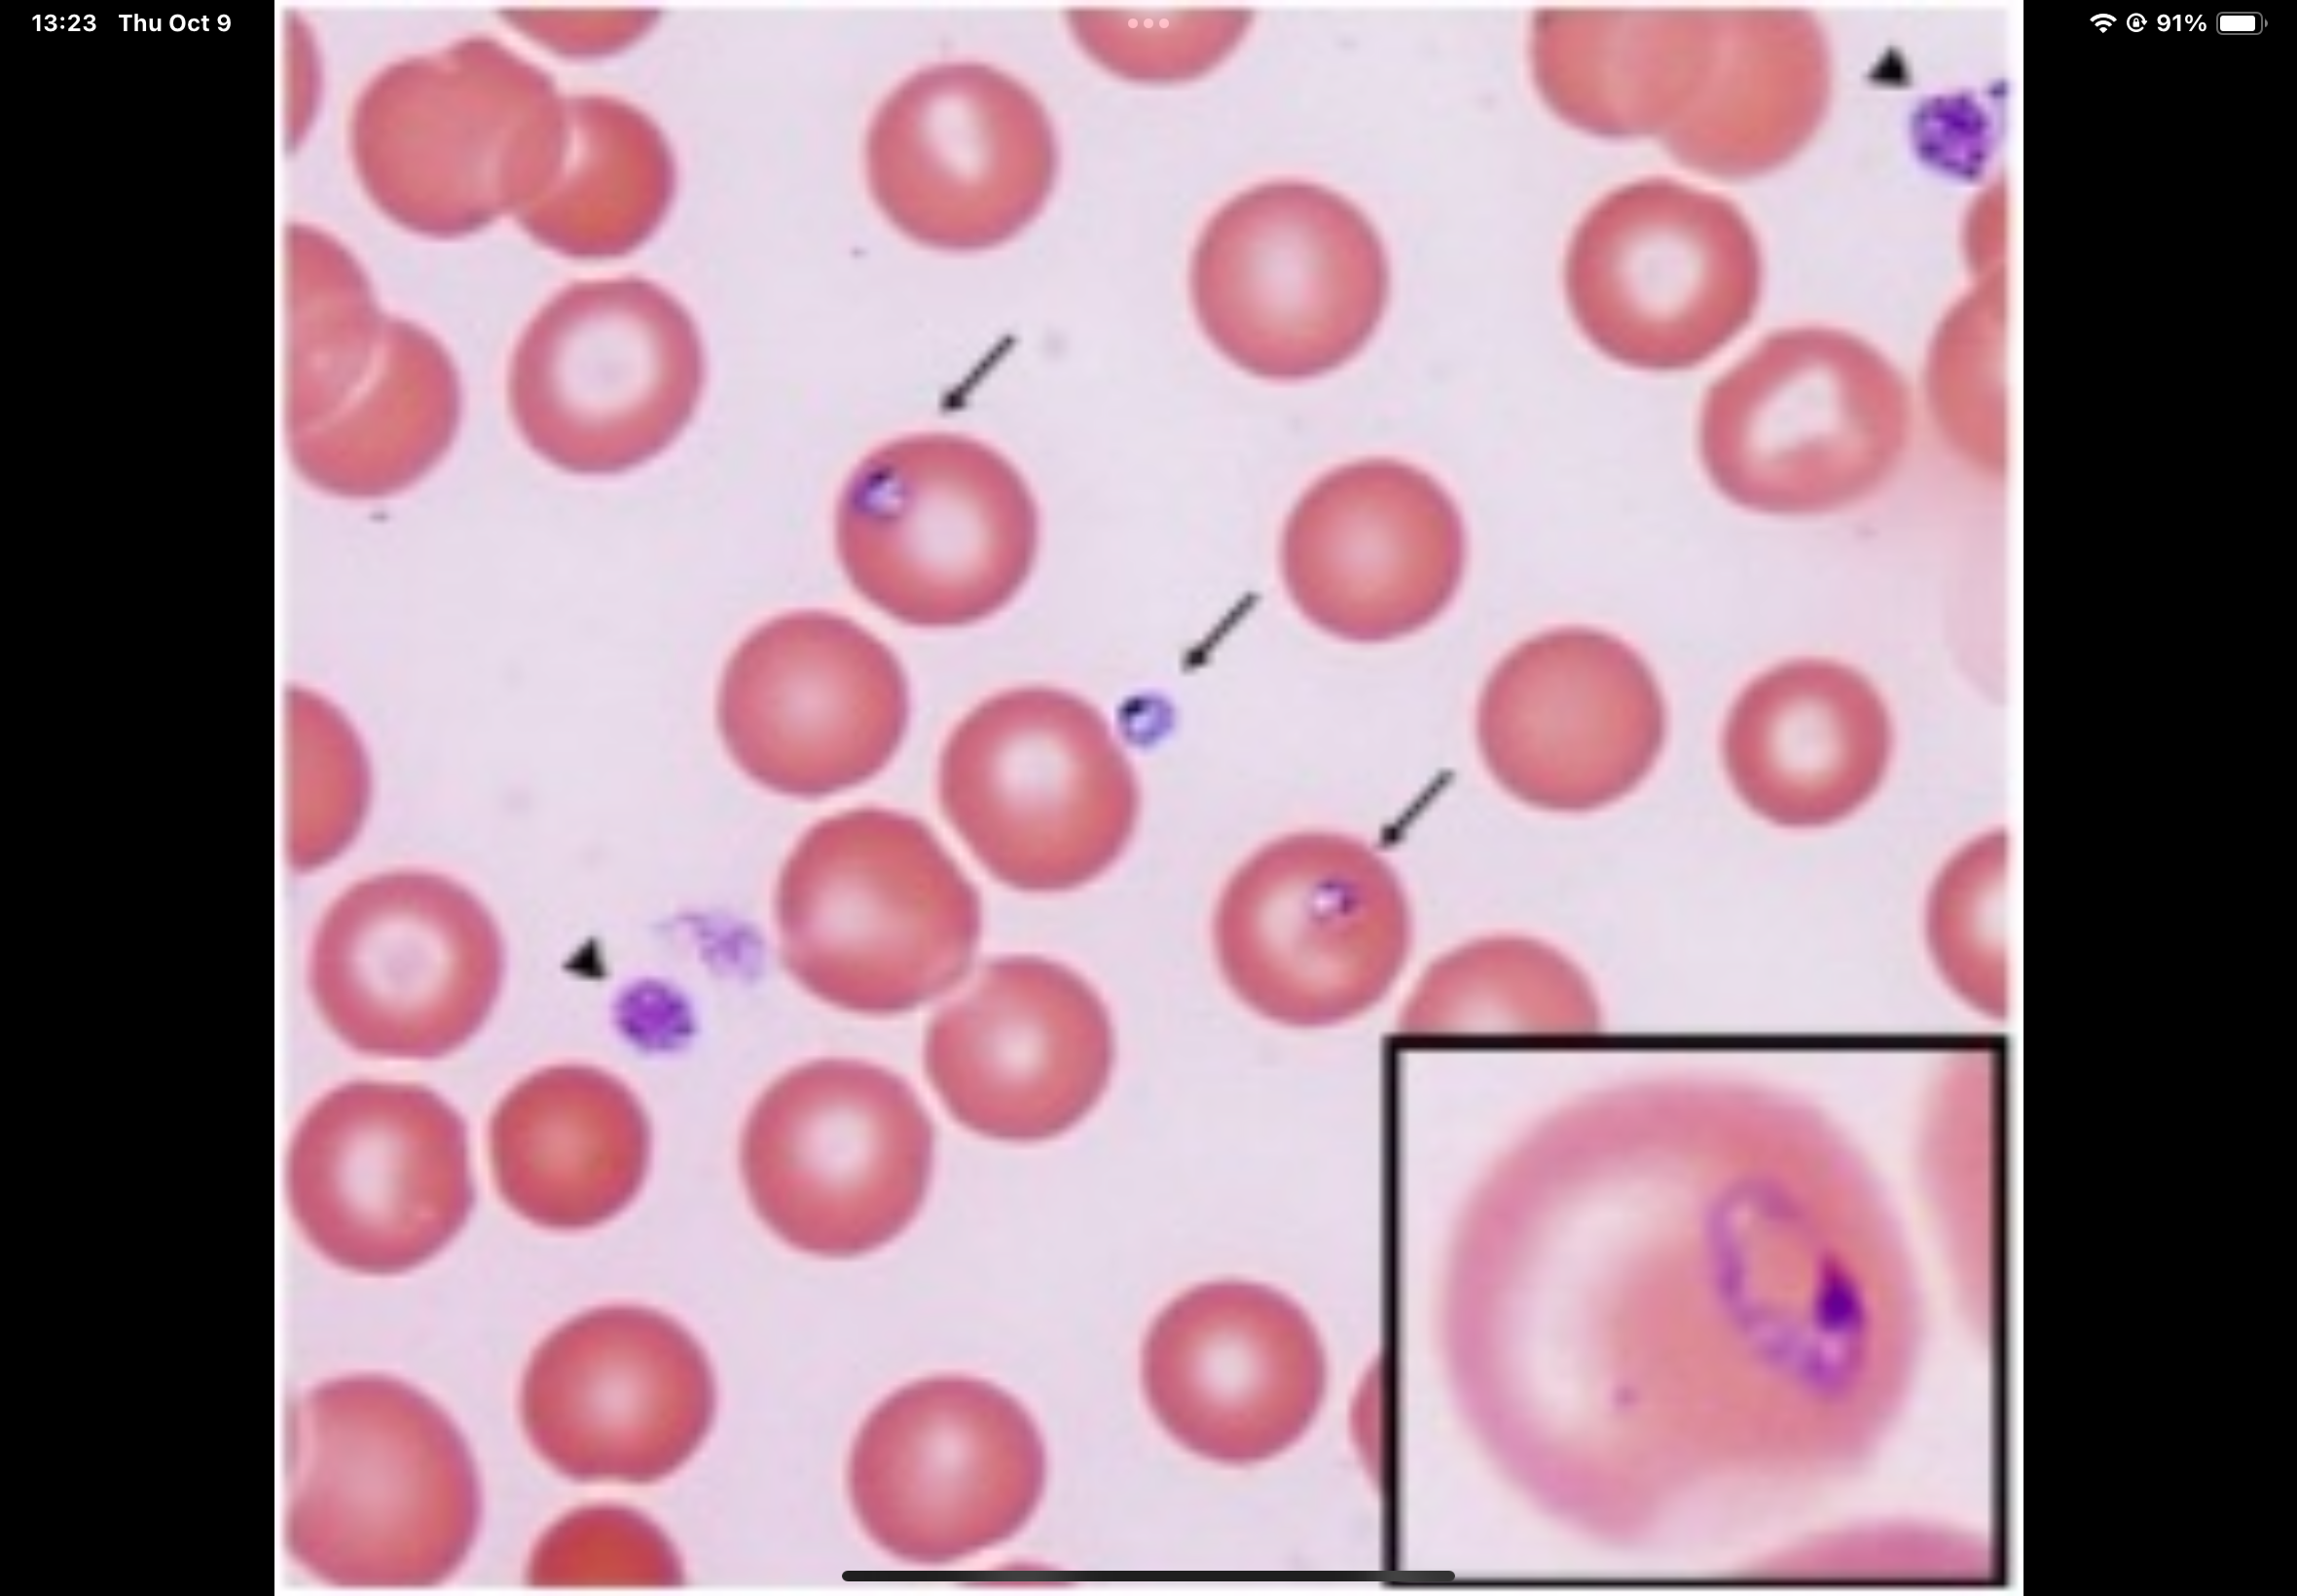

1/59
Looks like no tags are added yet.
Name | Mastery | Learn | Test | Matching | Spaced | Call with Kai |
|---|
No analytics yet
Send a link to your students to track their progress

Black pierda

Malassezia furfur

Dermatophytosis, trichophyton, microsporum, epidermophyton

Dermatophytosis, trichophyton, microsporum, epidermophyton (the foot)

Sporothrix schenckii

Cladophialophora

Acremonium

Aspergillus niger

Aspergillus niger (onion)

Stachybotrys chartarum

Stachybotrys chartarum (board)

Cryptococcus neoformans

Blastomyces dermatitidis

Mucor

Zygomycota

Coccidiodes immitis

Histoplasma capsulatum

Brown algae phaeophyta (kelp)

Red algae rhodophyta

Green algae chlorophyta

Trichonympha

Trichomonas vaginalis

Trichomonas vaginalis (blue)

Giardi lamblia

Giardi lamblia (blue)

Phylum euglenozoa

Phylum euglenozoa (dots)

Trypanosoma brucei

Trypanosoma cruzi

Trypanosoma cruzi (back)

Leishmania

Leishmania (worm)

Didinium

Cyclospora
Babesia

Cryptosporidium

Toxoplasma gondii

Pfiesteria

Gymnodinum

Gonyaulax

Naegleria fowleri

Acanthamoeba

Entamoeba histolytica

Schistosoma

Clonorchid

Cestodes or tapeworms

Cestodes or tapeworms (worm)

Taenia saginata

Taenia solium

Taenia solium (worm)

Dipylidium caninum

Dipylidium caninum (cluster worm)

Ascaris lumbricoides

Enterobius

Trichinella spiralis

Trichinella spiralis (tissue)

Necator americanus

Dirofilaria immitis